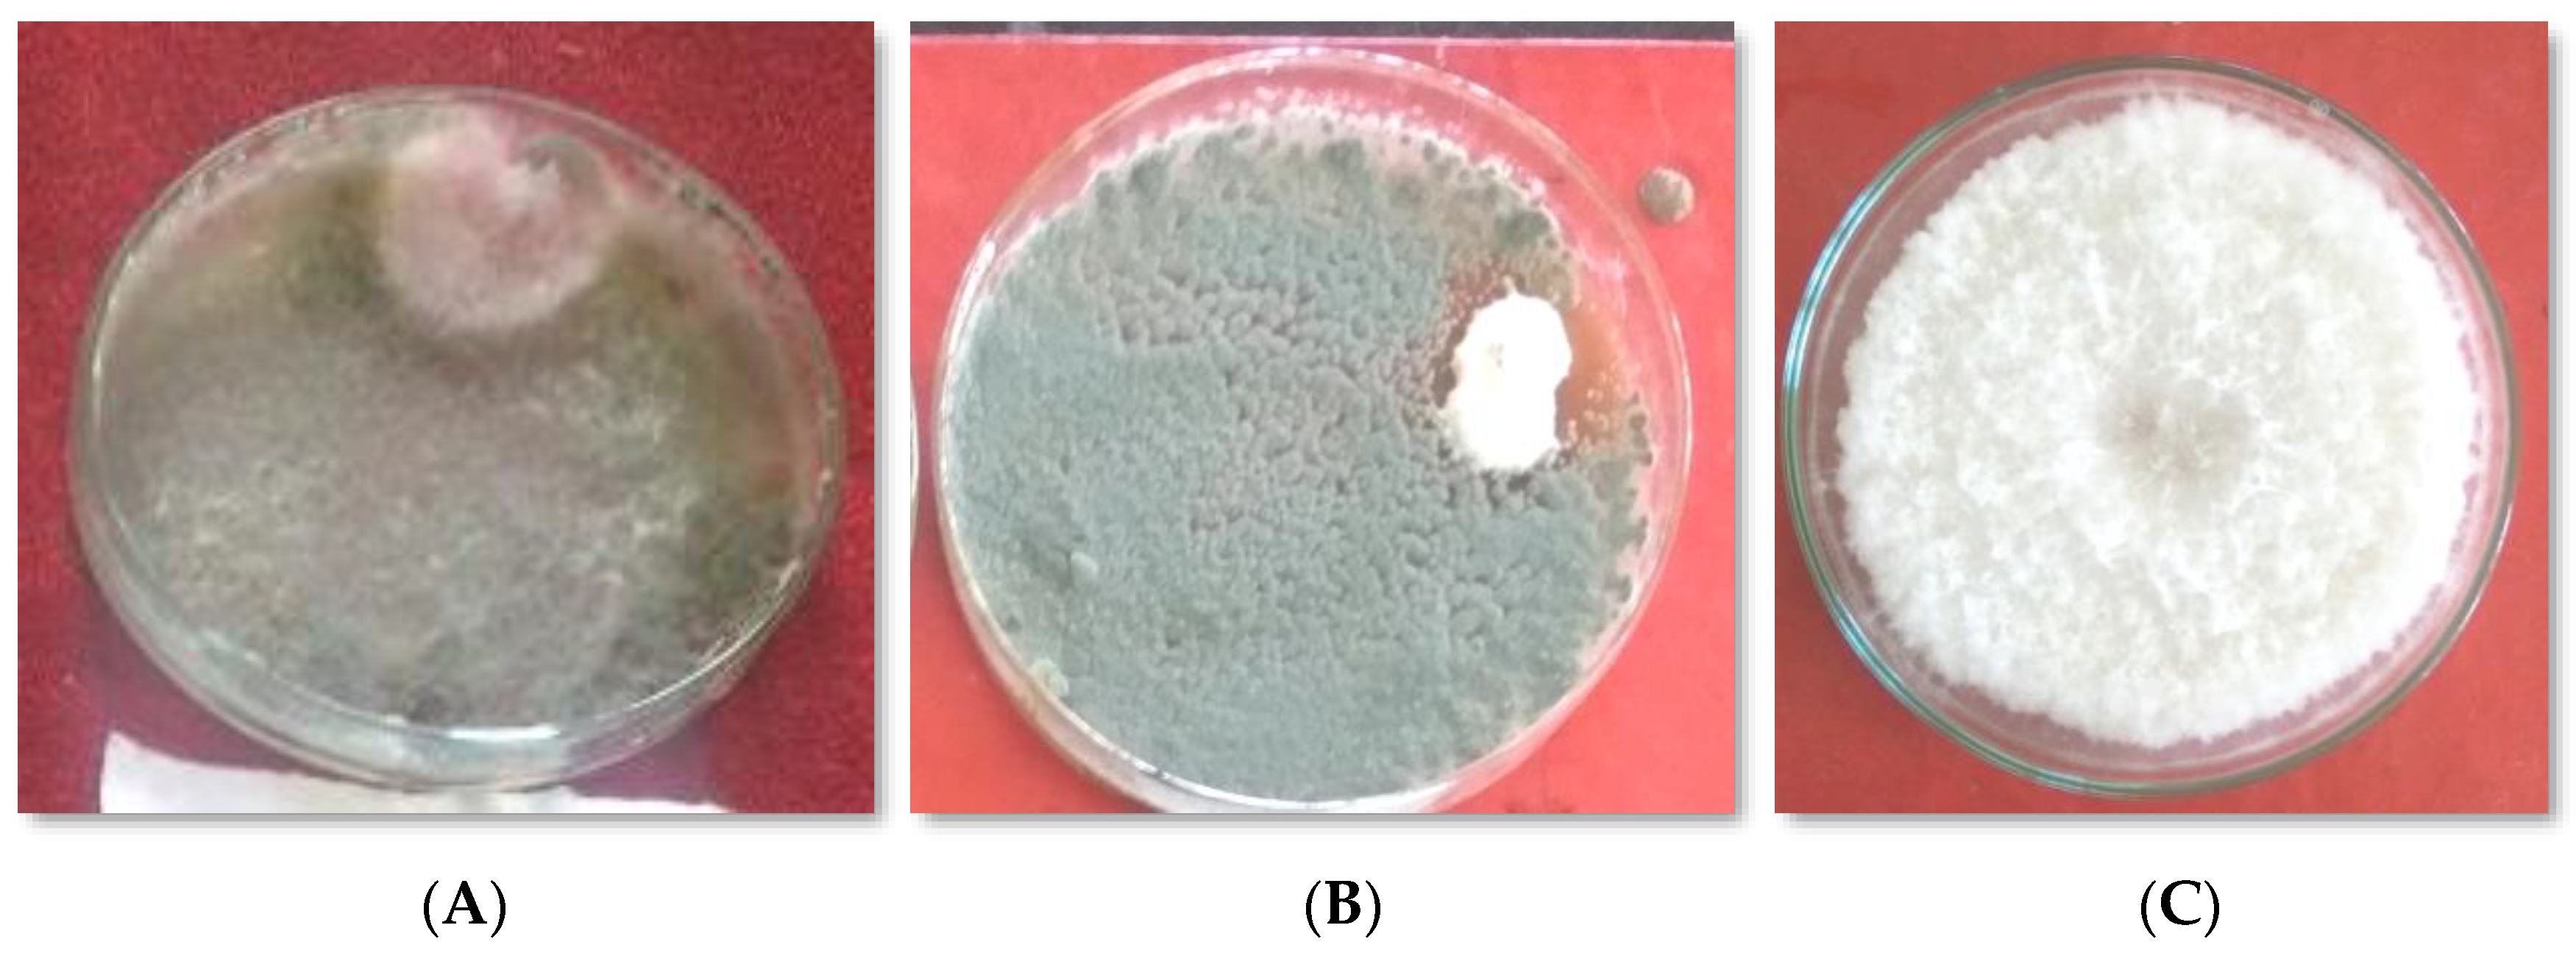
Horticulturae 07 00587 g006

Identification and Characterization of Triple Action Bioagents (TAB) and Their Potency against Fusarium Wilt of Lentil
Abstract
:1. Introduction
2. Materials and Methods
2.1. Isolation of Pathogen
2.2. Pathogenicity Test
2.3. Isolation of Copper Oxychloride Resistant Bioagents
2.4. Compatibility of Biocontrol Agents with Copper Oxychloride Fungicide In Vitro
2.5. In Vitro Screening of Isolated Biocontrol Agents against F. oxysporum f. sp.lentis
- I = Percent Inhibition;
- C = Colony diameter (mm) in control;
- T = Colony diameter (mm) in treatment.
2.6. Phosphorus Solubilizing Potential of Effective Biocontrol Agents
2.7. Identification of Potential Biocontrol Agents
2.8. Mass Multiplication of Potential Bioagents
2.9. Evaluation of Potential Copper Oxychloride Resistant Bioagents against Fusarium Wilt of Lentil in Pots
2.10. Disease Incidence
2.11. Disease Severity
- n = number of diseased plants observed;
- v = numerical grade value;
- N = total number of plants observed;
- G = highest grade value.
2.12. Statistical Analysis
3. Results
3.1. Pathogenicity and Morphological Characterization of the Isolated Pathogen
3.2. Isolation of Copper Oxychloride Resistant Biocontrol Agents
3.3. Compatibility of Biocontrol Agents with Fungicide
3.4. Dual Culture Assay
3.5. Phosphorus Solubilization Test of Effective Biocontrol Agents
3.6. Identification of Efficient Biocontrol Agents
3.7. Morphological Characteristics of Biocontrol Agents Trichoderma harzianum Isolate Skau-Tab-1 (TAB-1) and Penicillium crysogenum sp. Strain Tab-2 (TAB-2)
3.8. Evaluation of Efficient Copper Oxychloride Resistant Bioagents against Wilt Disease of Lentil in Pots
4. Discussion
5. Conclusions
Author Contributions
Funding
Institutional Review Board Statement
Informed Consent Statement
Data Availability Statement
Acknowledgments
Conflicts of Interest
Abbreviations
References
- Erskine, W.; Muehlbauer, F.; Sarker, A.; Sharma, B. Global production, supply and demand. In The Lentil: Botany, Production and Uses; Center for Legumes in Mediterranean Agriculture (CLIMA); University of Western Australia: Perth, Australian, 2009; p. 446. [Google Scholar]
- Hamadi, A.; Hassanein, A.M. Survey of fungal diseases of lentil in North Egypt. Lens Newsl. 1996, 2, 52–53. [Google Scholar]
- Garkoti, A.; Kumar, A.; Tripathi, H. Management of Fusarium wilt of lentil through fungicides. J. Mycol. Plant Pathol. 2013, 43, 333–335. [Google Scholar]
- Yadav, N.K.; Ghimire, S.K.; Shrestha, S.M.; Sah, B.P.; Sarker, A.; Sah, S.K. Source of resistant against Fusarium wilt and Stemphylium blight in lentil (Lens culinaris Medikus). Int. J. Appl. Sci. Biotechnol. 2017, 5, 102–107. [Google Scholar] [CrossRef]
- Singh, P. Lentil Wilt Caused by Fusarium oxysporum f. sp. lentis. Master’s Thesis, Jabalpur, Madhya Pradesh, India, 2015; pp. 45–46. [Google Scholar]
- Matthias, H. The rising threat of fungicide resistance in plant pathogenic fungi: Botrytis as a case study. J. Chem. Biol. 2014, 7, 133–141. [Google Scholar]
- Igbedioh, S.O. Effects of Agricultural Pesticides on Humans, Animals, and Higher Plants in Developing Countries. Arch. Environ. Health Int. J. 1991, 46, 218–224. [Google Scholar] [CrossRef] [PubMed]
- Ahmed, A. Biological Control of Potato Leaf Spot Disease Caused by Alternata alternata using Brevibacillus Formus Strain DSM 9885 and Brevibacillus brevis Strain NBRC 15304. J. Plant Pathol. Microbiol. 2017, 6, 1–8. [Google Scholar]
- Kulimushi, S.M.; Muiru, W.M.; Mutitu, E.W. Potential of Trichoderma spp., Bacillus subtilis and Pseudomonas fluorescens in the management of early blight in tomato. Biocontrol Sci. Technol. 2021, 31, 912–923. [Google Scholar] [CrossRef]
- Kumar, A.; Bansal, R.D.; Chelak, Y.K. Compatibility of Trichoderma viride with fungicides for Plant Disease Management. Int. J. Pure Appl. Biosci. 2019, 3, 44–51. [Google Scholar] [CrossRef]
- Seethiya, M.; Deepak, K.; Sing, S.K.; Deepak, M.; Kumar, D.; Shazia, P. Evaluation of Different Fungicides and Bioagents for the Management of Chickpea Wilt (Fusarium oxysporum f. sp. ciceri). Curr. J. Appl. Sci. Technol. 2020, 39, 19–30. [Google Scholar]
- Ravichandra, S.; Yashoda, H.R. Evaluation of fungicides against Fusarium oxysporium f. sp. ciceri causing chickpea wilt. Chem. Sci. Rev. Lett. 2015, 4, 1042–1046. [Google Scholar]
- Anand, R.; Kulothungan, S.; Sasikumar, G.M.; Bhuvaneshwari, K. Evaluating the fungicidal properties of copper oxychloride against Fusarium oxysporium the wilt pathogen of cotton. Asian J. Exp. Chem. 2008, 6, 70–72. [Google Scholar]
- Wadejo, B. Compatibility studies of fungicides with combination of Trichoderma species under in vitro conditions. Virol. Mycol. 2015, 4, 149. [Google Scholar] [CrossRef] [Green Version]
- Akter, F.; Ahmad, G.U.M.; Alam, M.F.; Begum, N. Biocontrol of lentil wilt disease by Trichoderma harzianum. Int. J. Agric. Environ. Biores. 2018, 3, 2456–8643. [Google Scholar]
- El Hassan, S.A.; Gowen, S.R.; Pembroke, P. Use of Trichoderma hamatum for biocontrol of lentil vascular wilt disease: Efficacy, mechanisms of interaction and future prospects. J. Plant Prot. Res. 2013, 53, 12–26. [Google Scholar] [CrossRef]
- Sicard, D.; Michalakis, Y.; Dron, M.; Neema, C. Genetic diversity and pathogenic variation of Colletotrichum lindemuthianum in three centers of diversity of its host, Phaseolus vulgaris. Phytopathology 1997, 87, 807–813. [Google Scholar] [CrossRef] [Green Version]
- Dubey, S.C.; Priyanka, K.; Singh, V.; Singh, B. Race profiling and molecular diversity analysis of Fusarium oxysporum f. sp. ciceris causing wilt in chickpea. J. Phytopathol. 2012, 160, 576–587. [Google Scholar] [CrossRef]
- Fravel, D.R. Commercialization and implementation of biocontrol. Annu. Rev. Phytopathol. 2005, 43, 337–359. [Google Scholar] [CrossRef]
- Zaidi, N.W.; Singh, U.S. An improved method for In vitro testing of antagonism. In National Symposium on Bio-Control Agents for Sustainable Management of Pests; Society of Plant Protection Science: New Delhi, India, 2003; pp. 81–82. [Google Scholar]
- Permono, M.E.; Moawad, A.M.; Vleck, P.L.G. Effect of phosphate solublizing Pseudomonas putida on the growth of maize and its survival in the rhizosphere. Crop Sci. 1996, 11, 13–23. [Google Scholar]
- Doyle, J.J.; Doyle, J.L. A rapid DNA isolation procedure to small amounts of fresh leaf tissue. Phytochem. Bull. 1987, 19, 11–15. [Google Scholar]
- Bayaa, B.; Erskine, W. A screening technique for resistance to vascular wilt in lentil. Arab J. Plant Prot. 1990, 8, 30–33. [Google Scholar]
- Suseela, R.; Thomas, J. Compatibility of Trichoderma harzianum with fungicides, insecticides and fertilizers. Indian Phytopathol. 2010, 63, 145–148. [Google Scholar]
- Poveda, J. Biological control of Fusarium oxysporum f. sp. ciceri and Ascochyta rabiei infecting protected geographical indication Fuentesaúco-Chickpea by Trichoderma species. Eur. J. Plant Pathol. 2021, 160, 825–840. [Google Scholar] [CrossRef]
- Poveda, J. Trichoderma parareesei favors the tolerance of rapeseed (Brassica napus L.) to salinity and drought due to a chorismate mutase. Agronomy 2020, 10, 118. [Google Scholar] [CrossRef] [Green Version]
- Bhatnagar, K.; Tak, S.K.; Sharma, R.S.; Majumdar, V.L.; Meena, R.L. Management of cumin wilt caused by Fusarium oxysporum f. sp. Cumini through chemical and biological agents. Indian Phytopathol. 2013, 66, 101–102. [Google Scholar]

| S. No. * | Isolate Code | Place of Collection | S. No. | Isolate Code | Place of Collection | S. No. | Isolate Code | Place of Collection |
|---|---|---|---|---|---|---|---|---|
| District Ganderbal | 23 | L3 | Behaama | 45 | H6 | Verinag | ||
| 1 | PH3 | Saloora | 24 | L4 | Behaama | 46 | H7 | Verinag |
| 2 | PH6 | Saloora | 25 | L5 | Behaama | 47 | H8 | Verinag |
| 3 | KG-1 | Saloora | 26 | L6 | Behaama | 49 | H10 | Verinag |
| 4 | KG-3 | Saloora | 27 | L7 | Behaama | 50 | M1 | Verinag |
| 5 | KG-4 | Saloora | 28 | L8 | Behaama | 51 | M8 | Verinag |
| 6 | P1 | Saloora | 29 | L9 | Behaama | 52 | M9 | Verinag |
| 7 | P2 | Saloora | District Anantnag | 53 | W9 | Verinag | ||
| 8 | P3 | Saloora | 30 | C1 | Verinag | 54 | W10 | Verinag |
| 9 | P5 | Saloora | 31 | C2 | Verinag | District Baramulla | ||
| 10 | P6 | Saloora | 32 | C3 | Verinag | 55 | M2 | Tarzoo |
| 11 | P8 | Saloora | 33 | C4 | Verinag | 56 | M3 | Tarzoo |
| 12 | O4 | Saloora | 34 | C5 | Verinag | 57 | M4 | Tarzoo |
| 13 | O2 | Saloora | 35 | C6 | Verinag | 59 | M5 | Tarzoo |
| 14 | O1 | Saloora | 36 | C7 | Verinag | 60 | M6 | Tarzoo |
| 15 | O3 | Saloora | 37 | C8 | Verinag | 61 | M7 | Tarzoo |
| 16 | O6 | Saloora | 38 | C9 | Verinag | 62 | M10 | Wadura |
| 17 | 05 | Saloora | 39 | C10 | Verinag | 65 | W1 | Wadura |
| 18 | O10 | Saloora | 40 | C16 | Verinag | 66 | W2 | Wadura |
| 19 | O5 | Saloora | 41 | Vn-1 | Verinag | 67 | W3 | Wadura |
| 20 | O9 | Saloora | 42 | Vn-2 | Verinag | 68 | W4 | Wadura |
| 21 | L1 | Saloora | 43 | H2 | Verinag | 69 | W5 | Wadura |
| 22 | L2 | Saloora | 44 | H3 | Verinag | 70 | W8 | Wadura |
| Scheme | Bioagents | Mean Radial Growth (mm) | S. No. | Bioagents | Mean Radial Growth (mm) |
|---|---|---|---|---|---|
| H10 | 69.00 * | 38. | KG-1 | 11.00 | |
| C9 | 65.00 | 39. | O5 | 10.60 | |
| PH3 | 62.00 | 40. | O9 | 9.50 | |
| P5 | 59.16 | 41. | L1 | 9.40 | |
| C4 | 56.16 | 42. | L2 | 9.16 | |
| O4 | 54.23 | 43. | L3 | 9.00 | |
| P3 | 51.30 | 44. | L4 | 9.40 | |
| VN-2 | 50.73 | 45. | L5 | 8.63 | |
| H6 | 46.93 | 46. | L6 | 8.10 | |
| C10 | 44.50 | 47. | L7 | 7.80 | |
| P2 | 40.33 | 48. | L8 | 7.40 | |
| P8 | 39.56 | 49. | L9 | 7.00 | |
| P6 | 37.50 | 50. | VN-1 | 6.70 | |
| C6 | 35.23 | 51. | C8 | 6.70 | |
| O2 | 33.53 | 52. | W4 | 6.40 | |
| C3 | 31.46 | 53. | W6 | 6.00 | |
| H2 | 29.76 | 54. | W7 | 5.56 | |
| C7 | 29.50 | 55. | W8 | 5.40 | |
| P1 | 27.00 | 56. | W9 | 4.90 | |
| C16 | 26.86 | 57. | W10 | 4.50 | |
| C5 | 25.70 | 58. | H7 | 4.00 | |
| O1 | 23.50 | 59. | PH-6 | 3.00 | |
| O3 | 21.70 | 60. | KG-4 | 2.90 | |
| C2 | 20.73 | 61. | M1 | 2.40 | |
| H3 | 18.93 | 62. | M2 | 2.06 | |
| H12 | 18.26 | 63. | M3 | 1.73 | |
| KG-3 | 18.13 | 64. | M4 | 1.66 | |
| O6 | 17.43 | 65. | M5 | 1.63 | |
| W3 | 15.80 | 66. | M6 | 1.40 | |
| P1 | 15.33 | 67. | M7 | 1.16 | |
| PH1 | 14.50 | 68. | M8 | 1.16 | |
| C8 | 13.96 | 69. | M9 | 1.11 | |
| LT | 12.86 | 70. | M10 | 1.00 | |
| O5 | 12.70 | C.D (p ≤ 0.05) | 1.3 | ||
| C1 | 11.96 | ||||
| O10 | 11.43 | ||||
| H8 | 11.13 | ||||
| Bioagents | Mean Colony Diameter of Pathogen (mm) | Mean % Inhibition | Bioagents | Mean Colony Diameter of Pathogen (mm) | Mean % Inhibition |
|---|---|---|---|---|---|
| H10 | 14.08 | 84.30 * (66.63) | O10 | 37.20 | 58.66 (49.96) |
| C9 | 14.41 | 83.94 (66.35) | H8 | 37.70 | 58.29 (49.75) |
| PH3 | 15.41 | 82.85 (65.51) | KG-1 | 38.40 | 57.33 (49.19) |
| P5 | 17.00 | 81.11 (64.21) | O5 | 39.16 | 56.47 (48.70) |
| C4 | 18.20 | 79.75 (63.23) | O9 | 40.00 | 55.55 (48.16) |
| O4 | 18.50 | 79.40 (62.98) | L1 | 40.33 | 55.18 (47.95) |
| P3 | 19.20 | 78.66 (62.46) | L2 | 40.53 | 54.94 (47.82) |
| VN-2 | 19.86 | 77.92 (61.94) | L3 | 40.83 | 54.95 (47.82) |
| H6 | 20.20 | 77.55 (61.69) | L4 | 41.43 | 54.29 (47.44) |
| C10 | 22.30 | 75.18 (60.09) | L5 | 43.53 | 51.62 (45.91) |
| P2 | 23.60 | 73.75 (59.12) | L6 | 45.66 | 49.25 (44.55) |
| P8 | 24.00 | 73.33 (58.88) | L7 | 46.66 | 48.14 (43.91) |
| P6 | 24.50 | 72.77 (58.16) | L8 | 47.76 | 46.92 (43.21) |
| C6 | 25.00 | 72.22 (57.81) | L9 | 48.80 | 45.77 (42.55) |
| O2 | 25.50 | 71.66 (57.69) | VN-1 | 49.73 | 44.73 (41.96) |
| C3 | 25.60 | 71.48 (57.09) | C8 | 50.70 | 43.66 (41.34) |
| H2 | 26.50 | 70.51 (56.76) | W4 | 52.43 | 41.73 (40.22) |
| C7 | 27.00 | 70.00 (56.53) | W6 | 54.00 | 40.00 (39.21) |
| P1 | 27.30 | 69.62 (55.91) | W7 | 56.20 | 37.55 (37.77) |
| C16 | 28.20 | 69.62 (55.57) | W8 | 58.90 | 34.55 (35.98) |
| C5 | 28.73 | 68.06 (55.38) | W9 | 59.80 | 33.55 (35.38) |
| O1 | 29.00 | 67.77 (55.00) | W10 | 61.90 | 31.21 (33.94) |
| O3 | 29.56 | 67.14 (54.53) | H7 | 64.50 | 28.33 (32.14) |
| C2 | 30.26 | 66.36 (54.23) | PH-6 | 65.13 | 27.62 (31.69) |
| H3 | 30.70 | 65.88 (53.77) | KG-4 | 66.96 | 25.58 (30.37) |
| H12 | 31.40 | 65.10 (53.26) | M1 | 69.83 | 22.40 (28.23) |
| KG-3 | 32.16 | 64.25 (53.01) | M2 | 72.13 | 17.62 (24.80) |
| O6 | 32.53 | 63.84 (52.68) | M3 | 75.33 | 16.29 (23.78) |
| W3 | 33.03 | 63.29 (52.22) | M4 | 76.30 | 15.22 (22.95) |
| P1 | 33.73 | 62.51 (52.09) | M5 | 76.93 | 14.51 (22.38) |
| PH1 | 33.93 | 62.29 (51.59) | M6 | 77.00 | 14.44 (22.32) |
| C8 | 34.70 | 61.44 (51.35) | M7 | 77.46 | 14.29 (22.20) |
| LT | 35.06 | 61.03 (50.92) | M8 | 77.80 | 13.55 (21.59) |
| O5 | 35.73 | 60.29 (50.42) | M9 | 78.50 | 12.77 (20.93) |
| C1 | 36.50 | 59.44 (49.96) | M10 | 79.26 | 11.92 (20.18) |
| O10 | 37.20 | 58.66 (49.96) | C.D (p ≤ 0.05) | 0.61 | |
| H8 | 37.70 | 58.29 (49.75) | |||
| S. No. | Isolates of Bioagents | * Mean Phosphate Solubilization Index (PSI) |
|---|---|---|
| 1 | C9 | 2.87 |
| 2 | H10 | 2.50 |
| 3 | PH3 | 2.25 |
| 4 | C4 | 2.00 |
| 5 | P6 | 1.75 |
| 6 | 05 | 1.61 |
| 7 | P5 | 1.48 |
| 8 | C10 | 1.35 |
| 9 | H6 | 1.26 |
| 10 | Vn-2 | 1.13 |
| C.D (p ≤ 0.05) | 0.22 |
| S. No. | Seed Treatment | 2017–2018 % Mean Disease Incidence | 2018–2019 % Mean Disease Incidence | Pooled % Mean Disease Incidence |
|---|---|---|---|---|
| 1 | TAB-1 + copper oxychloride | 3.24 (10.34) * | 5.64 (13.76) | 4.44 (9.97) |
| 2 | TAB-2 + copper oxychloride | 7.72 (16.12) | 5.62 (13.69) | 6.67 (14.96) |
| 3 | TAB-1 (Trichoderma) | 10.00 (18.42) | 12.2 (20.43) | 11.11 (19.25) |
| 4 | TAB-2 (Penicillium) | 13.85 (21.84) | 17.27 (24.54) | 15.55 (23.12) |
| 5 | Copper oxychloride | 21.32 (27.49) | 23.12 (28.72) | 22.22 (28.06) |
| 6 | Control | 81.94 (64.83) | 86.94 (68.79) | 84.44 (66.83) |
| C.D (p ≤ 0.05) | 0.835 | 0.815 | 3.07 | |
| S. No. | Seed Treatment | 2017–2018 % Mean Disease Intensity | 2018–2019 % Mean Disease Intensity | Pooled % Mean Disease Intensity |
|---|---|---|---|---|
| 1 | TAB-1 + copper oxychloride | 3.3 (10.42) * | 4.1 (11.66) | 3.7 (8.13) |
| 2 | TAB-2 + copper oxychloride | 4.74 (12.56) | 4.14 (11.70) | 4.44 (11.97) |
| 3 | TAB-1 (Trichoderma) | 9.48 (17.92) | 8.28 (16.71) | 8.88 (17.33) |
| 4 | TAB-2 (Penicillium) | 10.77 (19.14) | 9.97 (18.40) | 10.37 (18.77) |
| 5 | Copper oxychloride | 14.87 (22.67) | 13.27 (21.35) | 14.07 (22.00) |
| 6 | Control | 81.67 (64.62) | 80.21 (63.57) | 80.74 (59.35) |
| C.D (p ≤ 0.05) | 0.87 | 0.97 | 2.13 | |
Publisher’s Note: MDPI stays neutral with regard to jurisdictional claims in published maps and institutional affiliations. |
© 2021 by the authors. Licensee MDPI, Basel, Switzerland. This article is an open access article distributed under the terms and conditions of the Creative Commons Attribution (CC BY) license (https://creativecommons.org/licenses/by/4.0/).
Share and Cite
Nisa, R.T.; Bhat, K.A.; Basu, U.; Rashid, R.; Wang, X.; Jan, S.K.; Viswanath, H.S.; Soufan, W.; Mushtaq, M.; Rahman, M.H.u.; et al. Identification and Characterization of Triple Action Bioagents (TAB) and Their Potency against Fusarium Wilt of Lentil. Horticulturae 2021, 7, 587. https://doi.org/10.3390/horticulturae7120587
Nisa RT, Bhat KA, Basu U, Rashid R, Wang X, Jan SK, Viswanath HS, Soufan W, Mushtaq M, Rahman MHu, et al. Identification and Characterization of Triple Action Bioagents (TAB) and Their Potency against Fusarium Wilt of Lentil. Horticulturae. 2021; 7(12):587. https://doi.org/10.3390/horticulturae7120587
Chicago/Turabian StyleNisa, Raheeba Tun, Khurshid Ahmad Bhat, Umer Basu, Rameesa Rashid, Xiukang Wang, Shaheen Kauser Jan, H. S. Viswanath, Walid Soufan, Muntazir Mushtaq, Muhammad Habib ur Rahman, and et al. 2021. "Identification and Characterization of Triple Action Bioagents (TAB) and Their Potency against Fusarium Wilt of Lentil" Horticulturae 7, no. 12: 587. https://doi.org/10.3390/horticulturae7120587
APA StyleNisa, R. T., Bhat, K. A., Basu, U., Rashid, R., Wang, X., Jan, S. K., Viswanath, H. S., Soufan, W., Mushtaq, M., Rahman, M. H. u., Ahmad bhat, F., & EL Sabagh, A. (2021). Identification and Characterization of Triple Action Bioagents (TAB) and Their Potency against Fusarium Wilt of Lentil. Horticulturae, 7(12), 587. https://doi.org/10.3390/horticulturae7120587

